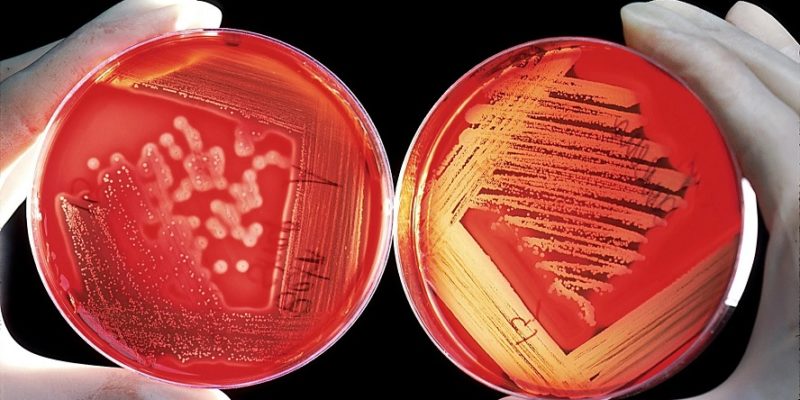

Japón, en alerta por cifras récord de infección de estreptococo
Tokio.- En Japón, el Instituto Nacional de Enfermedades Infecciosas (NIID) ha dado a conocer un aumento en los casos de infecciones graves provocadas por streptococcus o estreptococo.
Durante los dos primeros meses de 2024, se han registrado 378 casos, una cifra significativamente mayor que los 941 casos reportados en todo el año anterior.
Este incremento repentino sugiere la posibilidad de alcanzar cifras récord de infecciones hacia finales de este año en el país.
Las infecciones por streptococcus del grupo A, habitualmente asociadas con afecciones leves como la garganta irritada o la escarlatina, están adquiriendo un cariz más peligroso con la aparición del síndrome de shock tóxico estreptocócico (STSS).
Esta variante agresiva de la bacteria puede desencadenar problemas de salud graves como neumonía, meningitis e incluso la temida fascitis necrosante, con una tasa de mortalidad del 30%.
El profesor Takashi Nakano, experto en enfermedades infecciosas de la Escuela de Medicina de Kawasaki, señaló que aún existen numerosos aspectos por descubrir, como por ejemplo, qué provoca la virulencia de la bacteria.
El NIID (Instituto Nacional de Enfermedades Infecciosas) reconoció que todavía hay muchos factores desconocidos en relación a los mecanismos detrás de las formas severas y repentinas del estreptococo, y que en la actualidad no se cuenta con la capacidad para explicarlos.
Aunque las causas exactas del brusco aumento en los casos aún no han sido completamente identificadas, algunos expertos sugieren que la disminución de la inmunidad debido a las restricciones y relajaciones posteriores durante la pandemia de COVID-19 podrían estar contribuyendo a esta preocupante tendencia.